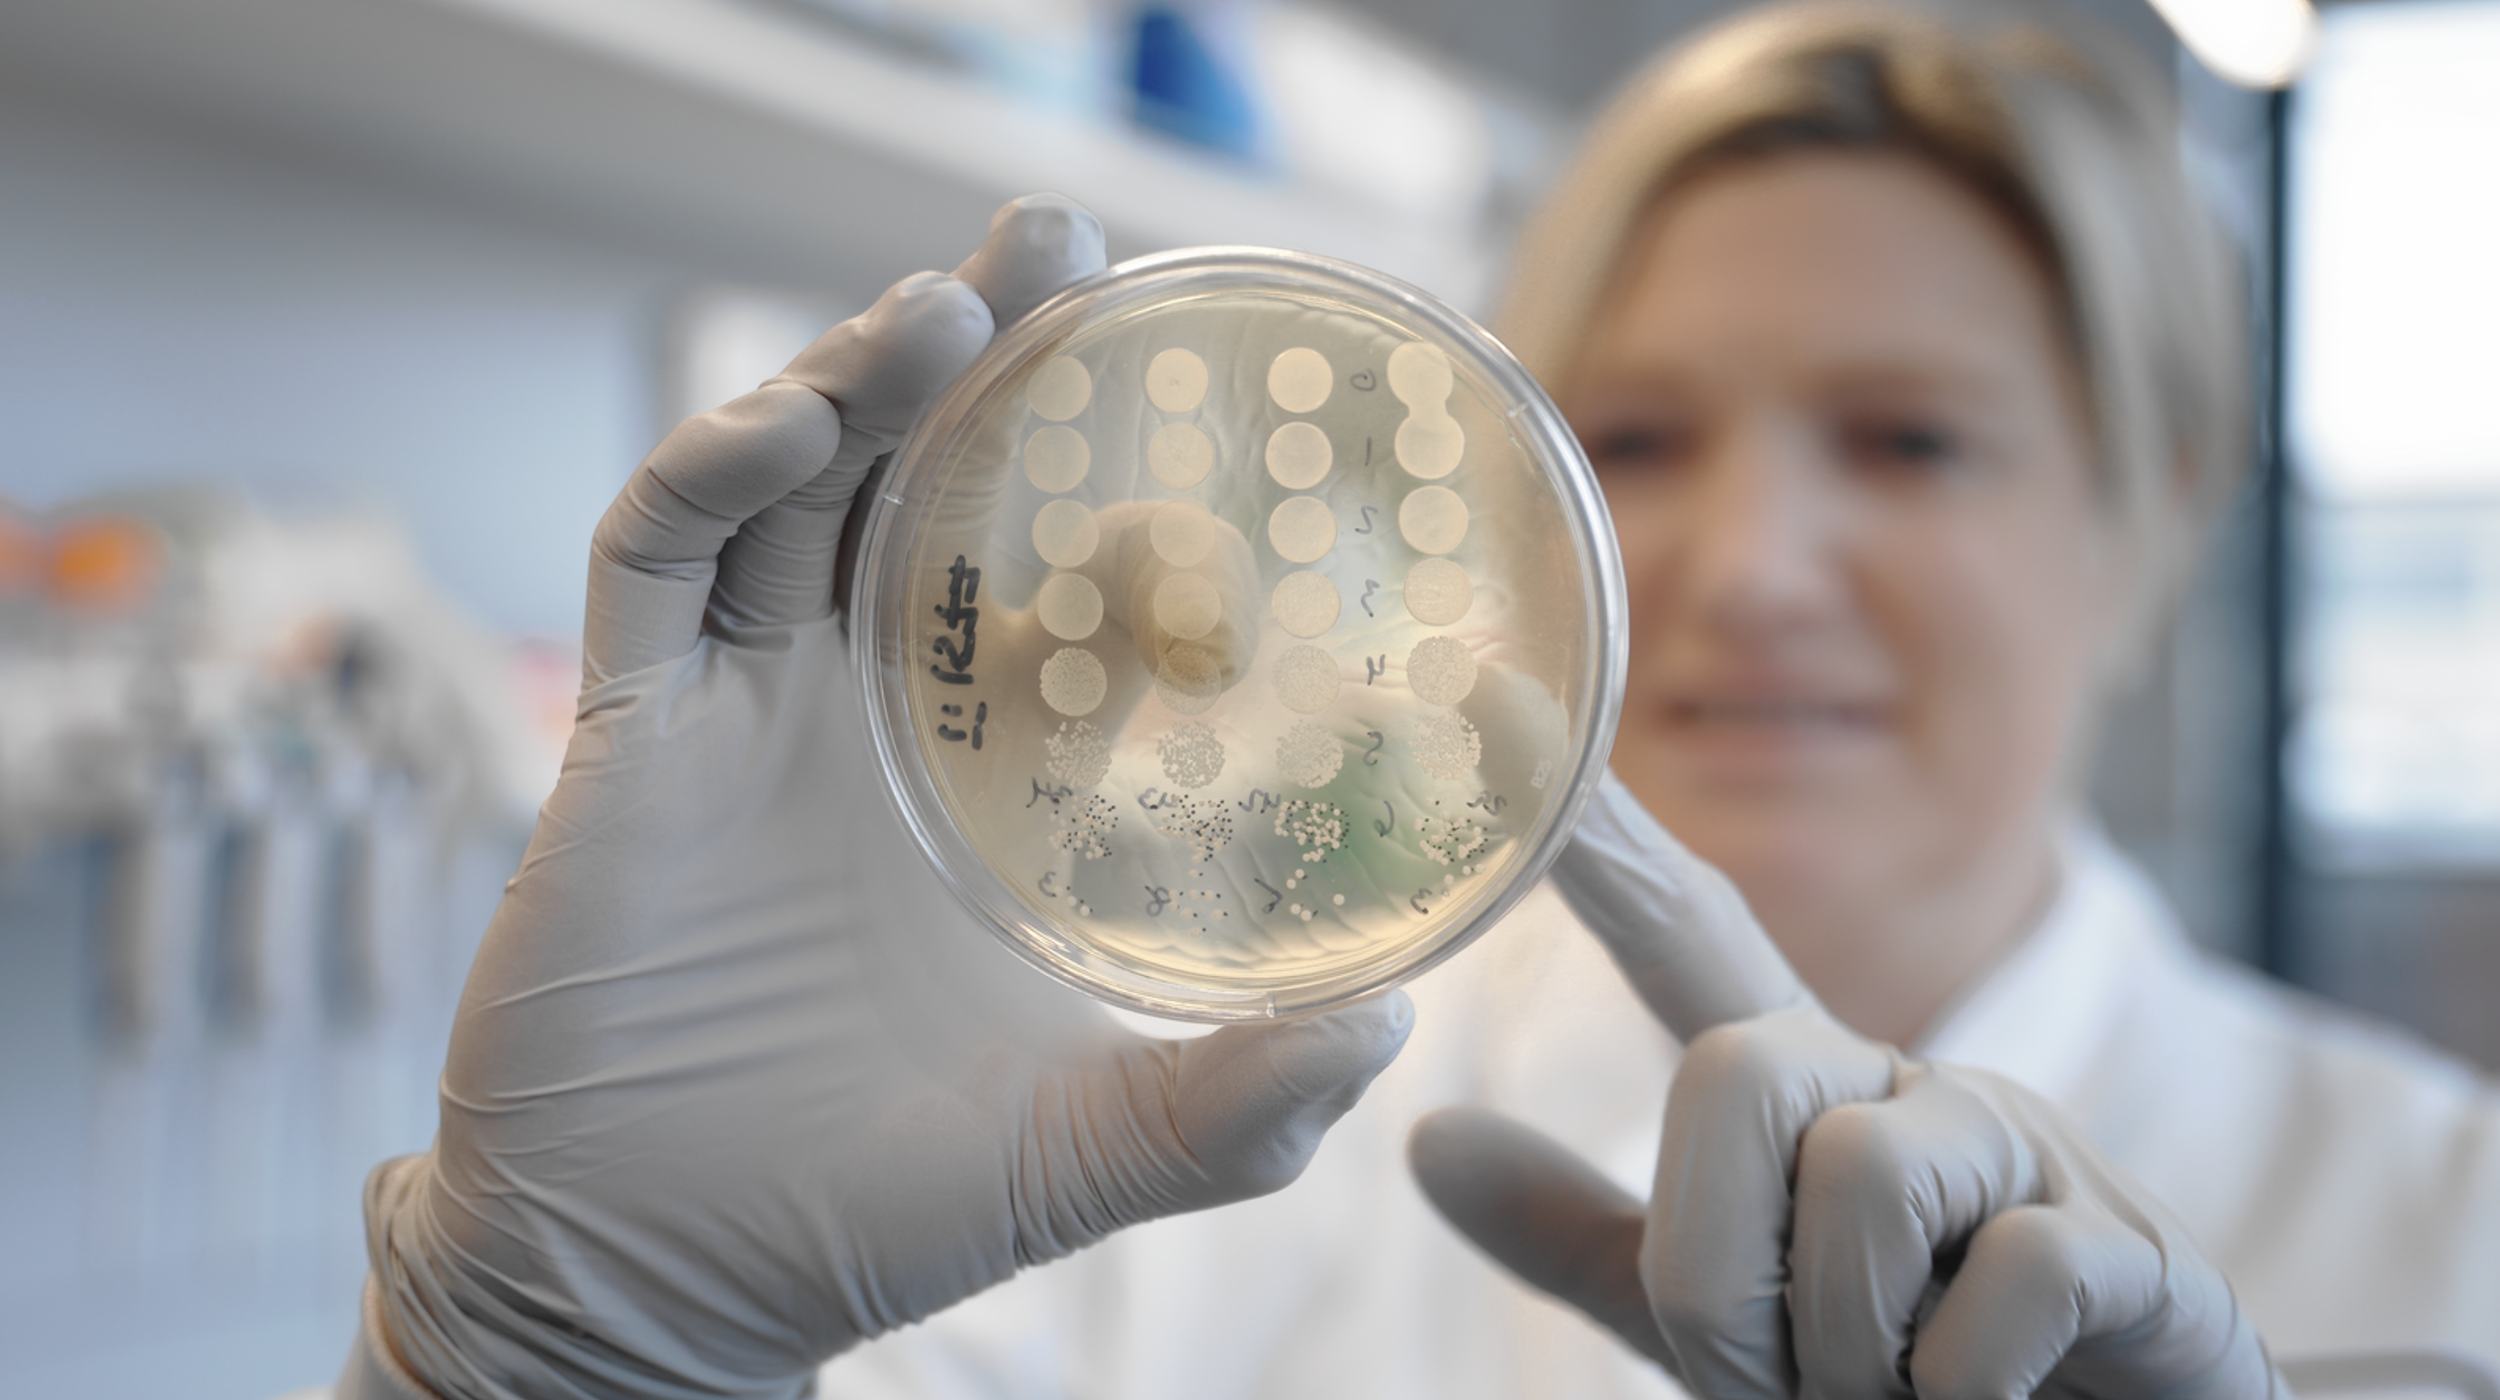

Portfolio
The Robot Whisperer
As the Freelance Creative Director for The Robot Whisperer, I led a full rebrand of the organization including logo updates, font and color refreshes, a custom website, video, and photo projects, and ongoing social media content creation.



Concerto Biosciences
I created fundraising videos, event coverage, founder portraits, team headshots, and social media content supporting both external communications and internal growth as Concerto Bioscience’s go-to Multimedia Media Producer.

Lab Automators
Through ongoing video and photography work with Lab Automators, I’ve supported the growth of a global event series by capturing live events, speakers, and community moments as the organization expanded from a simple idea to worldwide networking group.



Brizuela Fitness
I produced photo and video content for Brizuela Fitness, supporting client acquisition, trainer promotion, and the launch of a cohesive digital presence across platforms.



Festival of Genomics
For the multi-day Festival of Genomics conference, I led and contributed to a full suite of media production, including keynote recordings, event recap videos, photography, and an on-site headshot station.



Deep Eddy Vodka
I produced event recap videos and photography for Deep Eddy’s Beach Road Weekend music festival, creating content for their marketing team to use across digital platforms.



